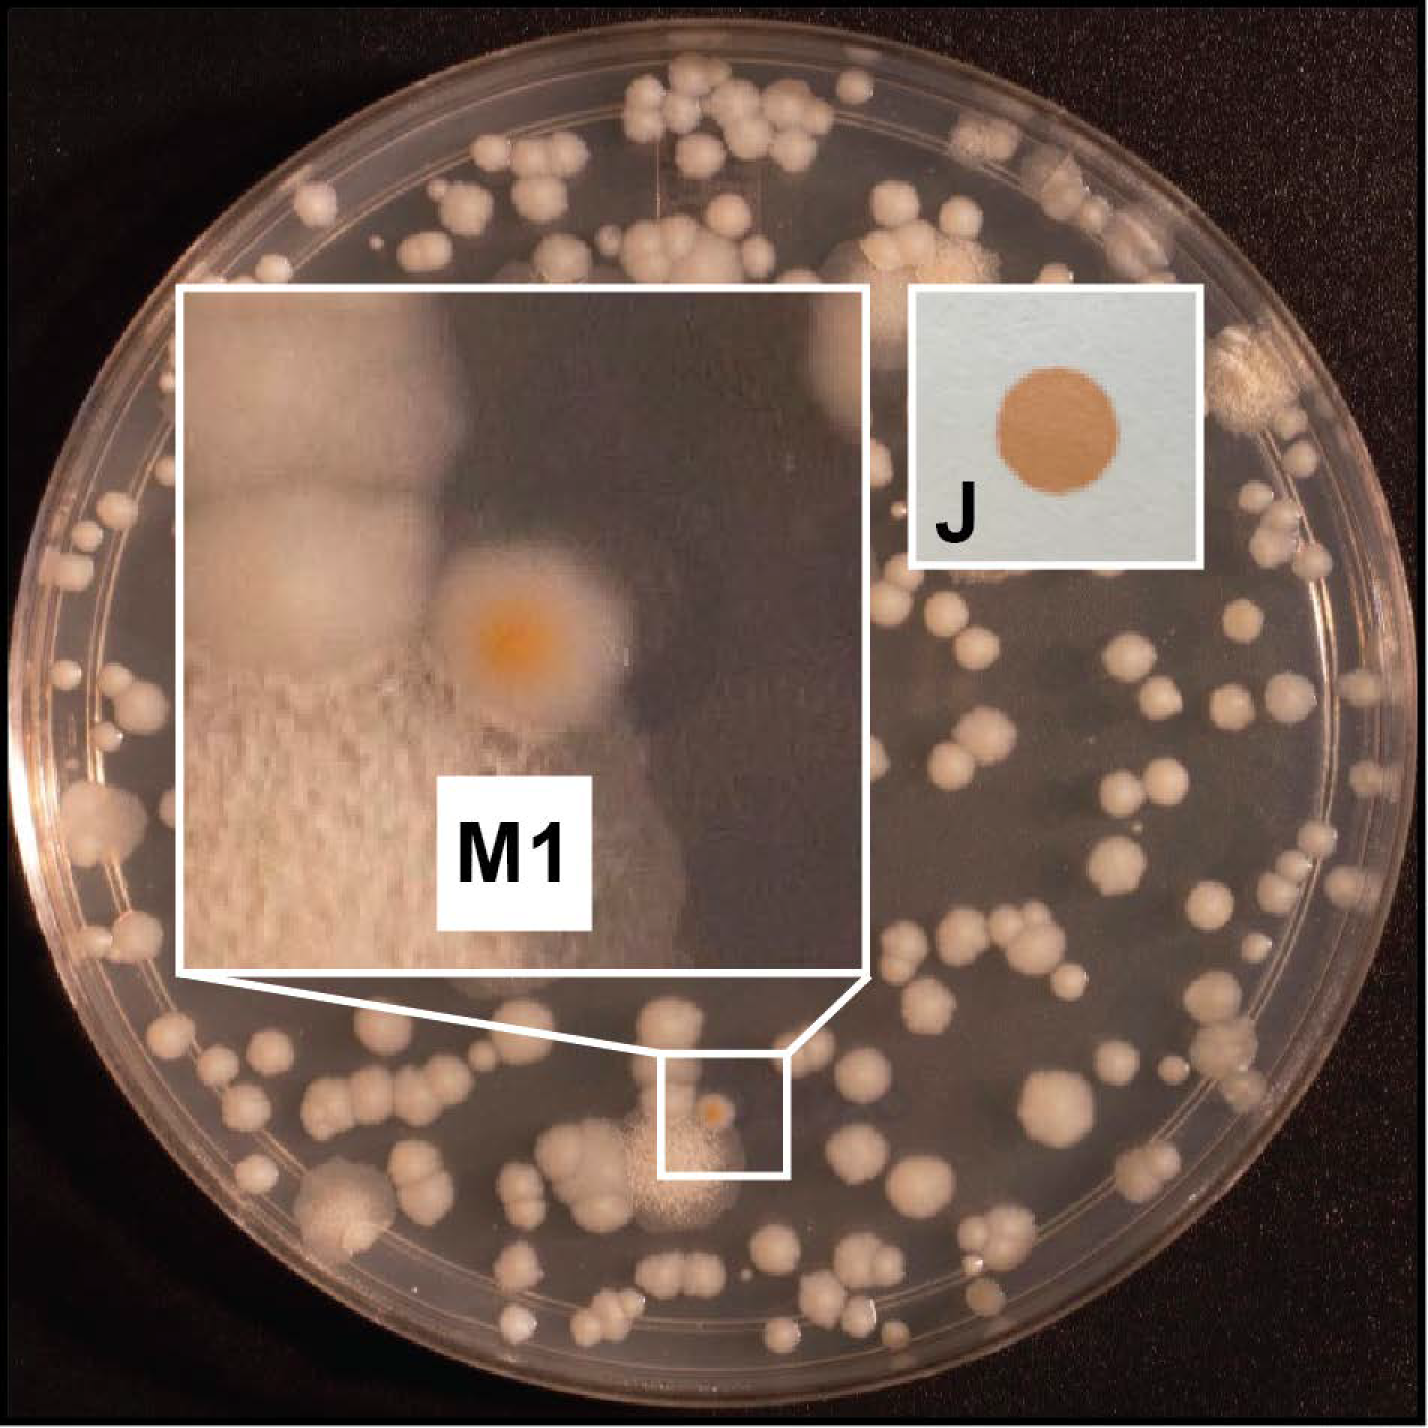
Pathogens 11 00953 g002

Mycobacterium abscessus Mutants with a Compromised Functional Link between the Type VII ESX-3 System and an Iron Uptake Mechanism Reliant on an Unusual Mycobactin Siderophore
Abstract
:1. Introduction
2. Results
2.1. Principle and Validation of the Screen for ESX-3-Impaired Mutants and Siderophore Production Probe
2.2. Large-Scale Screen and Genetic Characterization of Isolates with OP Phenotype
2.3. Colony and Macrocolony Phenotypes of Mutant Isolates

2.4. Sequence Bioinformatics Suggests the esx-3 Locus of M. abscessus Is Regulated in Response to Iron by IdeR


2.5. The Orange Pigmentation Phenotype of M. abscessus Cultures Is Influenced by Iron Availability
2.6. Growth Characterization of esx-3 Locus Mutants, M83MAB_4783, and M50MAB_2276c
2.7. Mass Spectrometry Analysis of M. abscessus Mycobactin
3. Discussion
4. Materials and Methods
4.1. Routine Culturing Conditions, Molecular Biology Techniques, and Reagents
4.2. Construction of Plasmid pMOD3Zeo and Preparation of EZ-Tn5-Derived Transposome
4.3. Generation and Screening of Mutant Libraries
4.4. Insertion Site Determination and Southern Blot Hybridization Analysis
4.5. Construction of Mycobacterial Gene Expression Plasmids
4.6. Sequence Bioinformatics
4.7. Growth Inhibition Assay
4.8. Determination of Mycobactin Production by Spectrophotometric and Radiometirc Assays
4.9. Mass Spectrometry Analysis of Mycobactins
5. Conclusions
Supplementary Materials
Author Contributions
Funding
Institutional Review Board Statement
Informed Consent Statement
Data Availability Statement
Acknowledgments
Conflicts of Interest
References
- Medjahed, H.; Gaillard, J.L.; Reyrat, J.M. Mycobacterium abscessus: A new player in the mycobacterial field. Trends Microbiol. 2010, 18, 117–123. [Google Scholar] [CrossRef] [PubMed]
- Mueller, P.S.; Edson, R.S. Disseminated Mycobacterium abscessus infection manifesting as fever of unknown origin and intra-abdominal lymphadenitis: Case report and literature review. Diagn. Microbiol. Infect. Dis. 2001, 39, 33–37. [Google Scholar] [CrossRef]
- Varghese, B.; Shajan, S.E.; Al, M.O.; Al-Hajoj, S.A. First case report of chronic pulmonary lung disease caused by Mycobacterium abscessus in two immunocompetent patients in Saudi Arabia. Ann. Saudi Med. 2012, 32, 312–314. [Google Scholar] [CrossRef] [PubMed]
- Petrini, B. Mycobacterium abscessus: An emerging rapid-growing potential pathogen. APMIS 2006, 114, 319–328. [Google Scholar] [CrossRef] [PubMed]
- Koh, W.J.; Jeon, K.; Lee, N.Y.; Kim, B.J.; Kook, Y.H.; Lee, S.H.; Park, Y.K.; Kim, C.K.; Shin, S.J.; Huitt, G.A.; et al. Clinical significance of differentiation of Mycobacterium massiliense from Mycobacterium abscessus. Am. J. Respir. Crit. Care Med. 2011, 183, 405–410. [Google Scholar] [CrossRef]
- Nessar, R.; Cambau, E.; Reyrat, J.M.; Murray, A.; Gicquel, B. Mycobacterium abscessus: A new antibiotic nightmare. J. Antimicrob. Chemother. 2012, 67, 810–818. [Google Scholar] [CrossRef] [PubMed]
- Tortoli, E.; Kohl, T.A.; Brown-Elliott, B.A.; Trovato, A.; Leao, S.C.; Garcia, M.J.; Vasireddy, S.; Turenne, C.Y.; Griffith, D.E.; Philley, J.V.; et al. Emended description of Mycobacterium abscessus, Mycobacterium abscessus subsp. abscessus and Mycobacterium abscessus subsp. bolletii and designation of Mycobacterium abscessus subsp. massiliense comb. nov. Int. J. Syst. Evol. Microbiol. 2016, 66, 4471–4479. [Google Scholar] [CrossRef] [PubMed]
- Ratnatunga, C.N.; Lutzky, V.P.; Kupz, A.; Doolan, D.L.; Reid, D.W.; Field, M.; Bell, S.C.; Thomson, R.M.; Miles, J.J. The rise of non-tuberculosis mycobacterial lung disease. Front. Immunol. 2020, 11, 303. [Google Scholar] [CrossRef]
- Daley, C.L.; Griffith, D.E. Pulmonary disease caused by rapidly growing mycobacteria. Clin. Chest Med. 2002, 23, 623–632. [Google Scholar] [CrossRef]
- Jeong, Y.J.; Lee, K.S.; Koh, W.J.; Han, J.; Kim, T.S.; Kwon, O.J. Nontuberculous mycobacterial pulmonary infection in immunocompetent patients: Comparison of thin-section CT and histopathologic findings. Radiology 2004, 231, 880–886. [Google Scholar] [CrossRef]
- Wang, C.C.; Lin, M.C.; Liu, J.W.; Wang, Y.H. Nontuberculous mycobacterial lung disease in southern Taiwan. Chang Gung Med. J. 2009, 32, 499–508. [Google Scholar] [PubMed]
- Redelman-Sidi, G.; Sepkowitz, K.A. Rapidly growing mycobacteria infection in patients with cancer. Clin. Infect. Dis. 2010, 51, 422–434. [Google Scholar] [CrossRef] [PubMed]
- Griffith, D.E.; Aksamit, T.; Brown-Elliott, B.A.; Catanzaro, A.; Daley, C.; Gordin, F.; Holland, S.M.; Horsburgh, R.; Huitt, G.; Iademarco, M.F.; et al. An official ATS/IDSA statement: Diagnosis, treatment, and prevention of nontuberculous mycobacterial diseases. Am. J. Respir. Crit. Care Med. 2007, 175, 367–416. [Google Scholar] [CrossRef] [PubMed]
- van Ingen, J.; Boeree, M.J.; van Soolingen, D.; Mouton, J.W. Resistance mechanisms and drug susceptibility testing of nontuberculous mycobacteria. Drug Resist. Updates 2012, 15, 149–161. [Google Scholar] [CrossRef]
- Bottai, D.; Serafini, A.; Cascioferro, A.; Brosch, R.; Manganelli, R. Targeting type VII/ESX secretion systems for development of novel antimycobacterial drugs. Curr. Pharm. Des. 2014, 20, 4346–4356. [Google Scholar] [CrossRef] [PubMed]
- Feltcher, M.E.; Sullivan, J.T.; Braunstein, M. Protein export systems of Mycobacterium tuberculosis: Novel targets for drug development? Future Microbiol. 2010, 5, 1581–1597. [Google Scholar] [CrossRef] [PubMed]
- Newton-Foot, M.; Warren, R.M.; Sampson, S.L.; van Helden, P.D.; Gey van Pittius, N.C. The plasmid-mediated evolution of the mycobacterial ESX (Type VII) secretion systems. BMC Evol. Biol. 2016, 16, 62. [Google Scholar] [CrossRef] [PubMed]
- Rivera-Calzada, A.; Famelis, N.; Llorca, O.; Geibel, S. Type VII secretion systems: Structure, functions and transport models. Nat. Rev. Microbiol. 2021, 19, 567–584. [Google Scholar] [CrossRef] [PubMed]
- Ates, L.S.; Houben, E.N.G.; Bitter, W. Type VII secretion: A highly versatile secretion system. Microbiol. Spectr. 2016, 4, 357–384. [Google Scholar] [CrossRef]
- Groschel, M.I.; Sayes, F.; Simeone, R.; Majlessi, L.; Brosch, R. ESX secretion systems: Mycobacterial evolution to counter host immunity. Nat. Rev. Microbiol. 2016, 14, 677–691. [Google Scholar] [CrossRef]
- Bitter, W.; Houben, E.N.; Bottai, D.; Brodin, P.; Brown, E.J.; Cox, J.S.; Derbyshire, K.; Fortune, S.M.; Gao, L.Y.; Liu, J.; et al. Systematic genetic nomenclature for type VII secretion systems. PLoS Pathog. 2009, 5, e1000507. [Google Scholar] [CrossRef] [PubMed]
- Serafini, A.; Pisu, D.; Palu, G.; Rodriguez, G.M.; Manganelli, R. The ESX-3 secretion system is necessary for iron and zinc homeostasis in Mycobacterium tuberculosis. PLoS ONE 2013, 8, e78351. [Google Scholar]
- Sassetti, C.M.; Boyd, D.H.; Rubin, E.J. Genes required for mycobacterial growth defined by high density mutagenesis. Mol. Microbiol. 2003, 48, 77–84. [Google Scholar] [CrossRef] [PubMed]
- Serafini, A.; Boldrin, F.; Palu, G.; Manganelli, R. Characterization of a Mycobacterium tuberculosis ESX-3 conditional mutant: Essentiality and rescue by iron and zinc. J. Bacteriol. 2009, 191, 6340–6344. [Google Scholar] [CrossRef] [PubMed]
- Siegrist, M.S.; Unnikrishnan, M.; McConnell, M.J.; Borowsky, M.; Cheng, T.Y.; Siddiqi, N.; Fortune, S.M.; Moody, D.B.; Rubin, E.J. Mycobacterial Esx-3 is required for mycobactin-mediated iron acquisition. Proc. Natl. Acad. Sci. USA 2009, 106, 18792–18797. [Google Scholar] [CrossRef]
- Siegrist, M.S.; Steigedal, M.; Ahmad, R.; Mehra, A.; Dragset, M.S.; Schuster, B.M.; Philips, J.A.; Carr, S.A.; Rubin, E.J. Mycobacterial Esx-3 requires multiple components for iron acquisition. mBio 2014, 5, e01073-14. [Google Scholar] [CrossRef]
- Maciag, A.; Dainese, E.; Rodriguez, G.M.; Milano, A.; Provvedi, R.; Pasca, M.R.; Smith, I.; Palu, G.; Riccardi, G.; Manganelli, R. Global analysis of the Mycobacterium tuberculosis Zur (FurB) regulon. J. Bacteriol. 2007, 189, 730–740. [Google Scholar] [CrossRef]
- Ilghari, D.; Lightbody, K.L.; Veverka, V.; Waters, L.C.; Muskett, F.W.; Renshaw, P.S.; Carr, M.D. Solution structure of the Mycobacterium tuberculosis EsxG.EsxH complex: Functional implications and comparisons with other M. tuberculosis Esx family complexes. J. Biol. Chem. 2011, 286, 29993–30002. [Google Scholar] [CrossRef]
- Sweeney, K.A.; Dao, D.N.; Goldberg, M.F.; Hsu, T.; Venkataswamy, M.M.; Henao-Tamayo, M.; Ordway, D.; Sellers, R.S.; Jain, P.; Chen, B.; et al. A recombinant Mycobacterium smegmatis induces potent bactericidal immunity against Mycobacterium tuberculosis. Nat. Med. 2011, 17, 1261–1268. [Google Scholar] [CrossRef]
- Billeskov, R.; Vingsbo-Lundberg, C.; Andersen, P.; Dietrich, J. Induction of CD8 T cells against a novel epitope in TB10.4: Correlation with mycobacterial virulence and the presence of a functional region of difference-1. J. Immunol. 2007, 179, 3973–3981. [Google Scholar] [CrossRef]
- Hervas-Stubbs, S.; Majlessi, L.; Simsova, M.; Morova, J.; Rojas, M.J.; Nouze, C.; Brodin, P.; Sebo, P.; Leclerc, C. High frequency of CD4+ T cells specific for the TB10.4 protein correlates with protection against Mycobacterium tuberculosis infection. Infect. Immun. 2006, 74, 3396–3407. [Google Scholar] [CrossRef] [PubMed]
- Skjot, R.L.; Brock, I.; Arend, S.M.; Munk, M.E.; Theisen, M.; Ottenhoff, T.H.; Andersen, P. Epitope mapping of the immunodominant antigen TB10.4 and the two homologous proteins TB10.3 and TB12.9, which constitute a subfamily of the esat-6 gene family. Infect. Immun. 2002, 70, 5446–5453. [Google Scholar] [CrossRef] [PubMed]
- Tufariello, J.M.; Chapman, J.R.; Kerantzas, C.A.; Wong, K.W.; Vilcheze, C.; Jones, C.M.; Cole, L.E.; Tinaztepe, E.; Thompson, V.; Fenyo, D.; et al. Separable roles for Mycobacterium tuberculosis ESX-3 effectors in iron acquisition and virulence. Proc. Natl. Acad. Sci. USA 2016, 113, E348–E357. [Google Scholar] [CrossRef] [PubMed]
- Zhang, L.; Hendrickson, R.C.; Meikle, V.; Lefkowitz, E.J.; Ioerger, T.R.; Niederweis, M. Comprehensive analysis of iron utilization by Mycobacterium tuberculosis. PLoS Pathog. 2020, 16, e1008337. [Google Scholar] [CrossRef] [PubMed]
- Quadri, L.E. Strategic paradigm shifts in the antimicrobial drug discovery process of the 21st century. Infect. Disord. Drug Targets 2007, 7, 230–237. [Google Scholar] [CrossRef] [PubMed]
- Kim, Y.S.; Yang, C.S.; Nguyen, L.T.; Kim, J.K.; Jin, H.S.; Choe, J.H.; Kim, S.Y.; Lee, H.M.; Jung, M.; Kim, J.M.; et al. Mycobacterium abscessus ESX-3 plays an important role in host inflammatory and pathological responses during infection. Microbes Infect. 2017, 19, 5–17. [Google Scholar] [CrossRef]
- Rifat, D.; Chen, L.; Kreiswirth, B.N.; Nuermberger, E.L. Genome-wide essentiality analysis of Mycobacterium abscessus by saturated transposon mutagenesis and deep sequencing. mBio 2021, 12, e0104921. [Google Scholar] [CrossRef]
- Bosne, S.; Levy-Frebault, V.V. Mycobactin analysis as an aid for the identification of Mycobacterium fortuitum and Mycobacterium chelonae subspecies. J. Clin. Microbiol. 1992, 30, 1225–1231. [Google Scholar] [CrossRef]
- Hall, R.M.; Ratledge, C. Mycobactins as chemotaxonomic characters for some rapidly growing mycobacteria. J. Gen. Microbiol. 1984, 130, 1883–1892. [Google Scholar] [CrossRef]
- Ripoll, F.; Pasek, S.; Schenowitz, C.; Dossat, C.; Barbe, V.; Rottman, M.; Macheras, E.; Heym, B.; Herrmann, J.L.; Daffe, M.; et al. Non mycobacterial virulence genes in the genome of the emerging pathogen Mycobacterium abscessus. PLoS ONE 2009, 4, e5660. [Google Scholar] [CrossRef]
- Quadri, L.E. Biosynthesis of mycobacterial lipids by polyketide synthases and beyond. Crit. Rev. Biochem. Mol. Biol. 2014, 49, 179–211. [Google Scholar] [CrossRef] [PubMed]
- Quadri, L.E.; Sello, J.; Keating, T.A.; Weinreb, P.H.; Walsh, C.T. Identification of a Mycobacterium tuberculosis gene cluster encoding the biosynthetic enzymes for assembly of the virulence-conferring siderophore mycobactin. Chem. Biol. 1998, 5, 631–645. [Google Scholar] [CrossRef]
- Chavadi, S.S.; Stirrett, K.L.; Edupuganti, U.R.; Sadhanandan, G.; Vergnolle, O.; Schumacher, E.; Martin, C.; Qiu, W.G.; Soll, C.E.; Quadri, L.E.N. Mutational and phylogenetic analyses of the mycobacterial mbt gene cluster. J. Bacteriol. 2011, 193, 5905–5913. [Google Scholar] [CrossRef] [PubMed]
- Bythrow, G.V.; Mohandas, P.; Guney, T.; Standke, L.C.; Germain, G.A.; Lu, X.; Ji, C.; Levendosky, K.; Chavadi, S.S.; Tan, D.S.; et al. Kinetic analyses of the siderophore biosynthesis inhibitor salicyl-AMS and analogues as MbtA inhibitors and antimycobacterial agents. Biochemistry 2019, 58, 833–847. [Google Scholar] [CrossRef] [PubMed]
- Ferreras, J.A.; Ryu, J.S.; Di Lello, F.; Tan, D.S.; Quadri, L.E. Small-molecule inhibition of siderophore biosynthesis in Mycobacterium tuberculosis and Yersinia pestis. Nat. Chem. Biol. 2005, 1, 29–32. [Google Scholar] [CrossRef] [PubMed]
- Ghosh, C.; Pal, S.; Patel, A.; Kapur, M. Total synthesis of the proposed structure of mycobactin J. Org. Lett. 2018, 20, 6511–6515. [Google Scholar] [CrossRef]
- DeJesus, M.A.; Gerrick, E.R.; Xu, W.; Park, S.W.; Long, J.E.; Boutte, C.C.; Rubin, E.J.; Schnappinger, D.; Ehrt, S.; Fortune, S.M.; et al. Comprehensive essentiality analysis of the Mycobacterium tuberculosis genome via saturating transposon mutagenesis. mBio 2017, 8, e02133-16. [Google Scholar] [CrossRef]
- Famelis, N.; Rivera-Calzada, A.; Degliesposti, G.; Wingender, M.; Mietrach, N.; Skehel, J.M.; Fernandez-Leiro, R.; Bottcher, B.; Schlosser, A.; Llorca, O.; et al. Architecture of the mycobacterial type VII secretion system. Nature 2019, 576, 321–325. [Google Scholar] [CrossRef]
- Poweleit, N.; Czudnochowski, N.; Nakagawa, R.; Trinidad, D.D.; Murphy, K.C.; Sassetti, C.M.; Rosenberg, O.S. The structure of the endogenous ESX-3 secretion system. eLife 2019, 8, e52983. [Google Scholar] [CrossRef]
- Jacobs, M.A.; Alwood, A.; Thaipisuttikul, I.; Spencer, D.; Haugen, E.; Ernst, S.; Will, O.; Kaul, R.; Raymond, C.; Levy, R.; et al. Comprehensive transposon mutant library of Pseudomonas aeruginosa. Proc. Natl. Acad. Sci. USA 2003, 100, 14339–14344. [Google Scholar] [CrossRef]
- Cameron, D.E.; Urbach, J.M.; Mekalanos, J.J. A defined transposon mutant library and its use in identifying motility genes in Vibrio cholerae. Proc. Natl. Acad. Sci. USA 2008, 105, 8736–8741. [Google Scholar] [CrossRef] [PubMed]
- Gallagher, L.A.; Ramage, E.; Patrapuvich, R.; Weiss, E.; Brittnacher, M.; Manoil, C. Sequence-defined transposon mutant library of Burkholderia thailandensis. mBio 2013, 4, e00604–e00613. [Google Scholar] [CrossRef] [PubMed]
- Gallagher, L.A.; Ramage, E.; Jacobs, M.A.; Kaul, R.; Brittnacher, M.; Manoil, C. A comprehensive transposon mutant library of Francisella novicida, a bioweapon surrogate. Proc. Natl. Acad. Sci. USA 2007, 104, 1009–1014. [Google Scholar] [CrossRef] [PubMed]
- Budell, W.C.; Germain, G.A.; Janisch, N.; McKie-Krisberg, Z.; Jayaprakash, A.D.; Resnick, A.E.; Quadri, L.E.N. Transposon mutagenesis in Mycobacterium kansasii links a small RNA gene to colony morphology and biofilm formation and identifies 9,885 intragenic insertions that do not compromise colony outgrowth. Microbiologyopen 2020, 9, e988. [Google Scholar] [CrossRef]
- Mohandas, P.; Budell, W.C.; Mueller, E.; Au, A.; Bythrow, G.V.; Quadri, L.E. Pleiotropic consequences of gene knockouts in the phthiocerol dimycocerosate and phenolic glycolipid biosynthetic gene cluster of the opportunistic human pathogen Mycobacterium marinum. FEMS Microbiol. Lett. 2016, 363, fnw016. [Google Scholar] [CrossRef]
- Maciag, A.; Piazza, A.; Riccardi, G.; Milano, A. Transcriptional analysis of ESAT-6 cluster 3 in Mycobacterium smegmatis. BMC Microbiol. 2009, 9, 48. [Google Scholar] [CrossRef]
- Gold, B.; Rodriguez, G.M.; Marras, S.A.; Pentecost, M.; Smith, I. The Mycobacterium tuberculosis IdeR is a dual functional regulator that controls transcription of genes involved in iron acquisition, iron storage and survival in macrophages. Mol. Microbiol. 2001, 42, 851–865. [Google Scholar] [CrossRef]
- Rodriguez, G.M.; Voskuil, M.I.; Gold, B.; Schoolnik, G.K.; Smith, I. ideR, an essential gene in Mycobacterium tuberculosis: Role of IdeR in iron-dependent gene expression, iron metabolism, and oxidative stress response. Infect. Immun. 2002, 70, 3371–3381. [Google Scholar] [CrossRef]
- Yellaboina, S.; Ranjan, S.; Vindal, V.; Ranjan, A. Comparative analysis of iron regulated genes in mycobacteria. FEBS Lett. 2006, 580, 2567–2576. [Google Scholar] [CrossRef]
- Janagama, H.K.; Senthilkumar, T.M.A.; Bannantine, J.P.; Rodriguez, G.M.; Smith, I.; Paustian, M.L.; McGarvey, J.A.; Sreevatsan, S. Identification and functional characterization of the iron-dependent regulator (IdeR) of Mycobacterium avium subsp. paratuberculosis. Microbiology 2009, 155, 3683–3690. [Google Scholar] [CrossRef]
- Prakash, P.; Yellaboina, S.; Ranjan, A.; Hasnain, S.E. Computational prediction and experimental verification of novel IdeR binding sites in the upstream sequences of Mycobacterium tuberculosis open reading frames. Bioinformatics 2005, 21, 2161–2166. [Google Scholar] [CrossRef] [PubMed]
- Knobloch, P.; Koliwer-Brandl, H.; Arnold, F.M.; Hanna, N.; Gonda, I.; Adenau, S.; Personnic, N.; Barisch, C.; Seeger, M.A.; Soldati, T.; et al. Mycobacterium marinum produces distinct mycobactin and carboxymycobactin siderophores to promote growth in broth and phagocytes. Cell. Microbiol. 2020, 22, e13163. [Google Scholar] [CrossRef] [PubMed]
- De Voss, J.J.; Rutter, K.; Schroeder, B.G.; Barry, C.E. Iron acquisition and metabolism by mycobacteria. J. Bacteriol. 1999, 181, 4443–4451. [Google Scholar] [CrossRef] [PubMed]
- Krithika, R.; Marathe, U.; Saxena, P.; Ansari, M.Z.; Mohanty, D.; Gokhale, R.S. A genetic locus required for iron acquisition in Mycobacterium tuberculosis. Proc. Natl. Acad. Sci. USA 2006, 103, 2069–2074. [Google Scholar] [CrossRef] [PubMed]
- Madigan, C.A.; Martinot, A.J.; Wei, J.R.; Madduri, A.; Cheng, T.Y.; Young, D.C.; Layre, E.; Murry, J.P.; Rubin, E.J.; Moody, D.B. Lipidomic analysis links mycobactin synthase K to iron uptake and virulence in M. tuberculosis. PLoS Pathog. 2015, 11, e1004792. [Google Scholar] [CrossRef]
- Li, W.; He, J.; Xie, L.; Chen, T.; Xie, J. Comparative genomic insights into the biosynthesis and regulation of mycobacterial siderophores. Cell. Physiol. Biochem. 2013, 31, 1–13. [Google Scholar] [CrossRef] [PubMed]
- Gold, B.; Warrier, T.; Nathan, C. A multi-stress model for high throughput screening against non-replicating Mycobacterium tuberculosis. Methods Mol. Biol. 2015, 1285, 293–315. [Google Scholar]
- Joshi, H.; Dave, R.; Venugopalan, V.P. Protein as chemical cue: Non-nutritional growth enhancement by exogenous protein in Pseudomonas putida KT2440. PLoS ONE 2014, 9, e103730. [Google Scholar]
- Konopka, K.; Neilands, J.B. Effect of serum albumin on siderophore-mediated utilization of transferrin iron. Biochemistry 1984, 23, 2122–2127. [Google Scholar] [CrossRef]
- Ekiert, D.C.; Cox, J.S. Structure of a PE-PPE-EspG complex from Mycobacterium tuberculosis reveals molecular specificity of ESX protein secretion. Proc. Natl. Acad. Sci. USA 2014, 111, 14758–14763. [Google Scholar] [CrossRef]
- Tuukkanen, A.T.; Freire, D.; Chan, S.; Arbing, M.A.; Reed, R.W.; Evans, T.J.; Zenkeviciute, G.; Kim, J.; Kahng, S.; Sawaya, M.R.; et al. Structural variability of EspG chaperones from mycobacterial ESX-1, ESX-3, and ESX-5 type VII secretion systems. J. Mol. Biol. 2019, 431, 289–307. [Google Scholar] [CrossRef] [PubMed]
- Dumas, E.; Christina Boritsch, E.; Vandenbogaert, M.; Rodriguez de la Vega, R.C.; Thiberge, J.M.; Caro, V.; Gaillard, J.L.; Heym, B.; Girard-Misguich, F.; Brosch, R.; et al. Mycobacterial pan-genome analysis suggests important role of plasmids in the radiation of type VII secretion systems. Genome Biol. Evol. 2016, 8, 387–402. [Google Scholar] [CrossRef] [PubMed]
- Lightbody, K.L.; Ilghari, D.; Waters, L.C.; Carey, G.; Bailey, M.A.; Williamson, R.A.; Renshaw, P.S.; Carr, M.D. Molecular features governing the stability and specificity of functional complex formation by Mycobacterium tuberculosis CFP-10/ESAT-6 family proteins. J. Biol. Chem. 2008, 283, 17681–17690. [Google Scholar] [CrossRef]
- Renshaw, P.S.; Lightbody, K.L.; Veverka, V.; Muskett, F.W.; Kelly, G.; Frenkiel, T.A.; Gordon, S.V.; Hewinson, R.G.; Burke, B.; Norman, J.; et al. Structure and function of the complex formed by the tuberculosis virulence factors CFP-10 and ESAT-6. EMBO J. 2005, 24, 2491–2498. [Google Scholar] [CrossRef] [PubMed]
- Gaur, A.; Sharma, V.K.; Shree, S.; Rai, N.; Ramachandran, R. Characterization of EccA3, a CbbX family ATPase from the ESX-3 secretion pathway of M. tuberculosis. Biochim. Biophys. Acta Proteins Proteom. 2017, 1865, 715–724. [Google Scholar] [CrossRef]
- DeJesus, M.A.; Zhang, Y.J.; Sassetti, C.M.; Rubin, E.J.; Sacchettini, J.C.; Ioerger, T.R. Bayesian analysis of gene essentiality based on sequencing of transposon insertion libraries. Bioinformatics 2013, 29, 695–703. [Google Scholar] [CrossRef]
- Chao, M.C.; Pritchard, J.R.; Zhang, Y.J.; Rubin, E.J.; Livny, J.; Davis, B.M.; Waldor, M.K. High-resolution definition of the Vibrio cholerae essential gene set with Hidden Markov Model-based analyses of transposon-insertion sequencing data. Nucleic Acids Res. 2013, 41, 9033–9048. [Google Scholar] [CrossRef]
- Luo, M.; Fadeev, E.A.; Groves, J.T. Mycobactin-mediated iron acquisition within macrophages. Nat. Chem. Biol. 2005, 1, 149–153. [Google Scholar] [CrossRef]
- Chavadi, S.S.; Edupuganti, U.R.; Vergnolle, O.; Fatima, I.; Singh, S.M.; Soll, C.E.; Quadri, L.E. Inactivation of tesA reduces cell-wall lipid production and increases drug susceptibility in mycobacteria. J. Biol. Chem. 2011, 286, 24616–24625. [Google Scholar] [CrossRef]
- Sambrook, J.; Russell, D.W. Molecular Cloning: A Laboratory Manual, 3rd ed.; Cold Spring Harbor Pres: Cold Spring Harbor, NY, USA, 2001. [Google Scholar]
- Medjahed, H.; Singh, A.K. Genetic manipulation of Mycobacterium abscessus. In Current Protocols in Microbiology; John Wiley & Sons, Inc.: New York, NY, USA, 2010. [Google Scholar]
- Barkan, D.; Stallings, C.L.; Glickman, M.S. An improved counterselectable marker system for mycobacterial recombination using galK and 2-deoxy-galactose. Gene 2011, 470, 31–36. [Google Scholar] [CrossRef]
- Orosz, A.; Boros, I.; Venetianer, P. Analysis of the complex transcription termination region of the Escherichia coli rrnB gene. Eur. J. Biochem. 1991, 201, 653–659. [Google Scholar] [CrossRef] [PubMed]
- Goude, R.; Roberts, D.M.; Parish, T. Electroporation of mycobacteria. Methods. Mol. Biol. 2015, 1285, 117–130. [Google Scholar] [PubMed]
- Guo, X.V.; Monteleone, M.; Klotzsche, M.; Kamionka, A.; Hillen, W.; Braunstein, M.; Ehrt, S.; Schnappinger, D. Silencing Mycobacterium smegmatis by using tetracycline repressors. J. Bacteriol. 2007, 189, 4614–4623. [Google Scholar] [CrossRef]
- Vick, J.E.; Johnson, E.T.; Choudhary, S.; Bloch, S.E.; Lopez-Gallego, F.; Srivastava, P.; Tikh, I.B.; Wawrzyn, G.T.; Schmidt-Dannert, C. Optimized compatible set of BioBrick vectors for metabolic pathway engineering. Appl. Microbiol. Biotechnol. 2011, 92, 1275–1286. [Google Scholar] [CrossRef] [PubMed]
- Huff, J.; Czyz, A.; Landick, R.; Niederweis, M. Taking phage integration to the next level as a genetic tool for mycobacteria. Gene 2010, 468, 8–19. [Google Scholar] [CrossRef] [PubMed]
- George, K.M.; Yuan, Y.; Sherman, D.R.; Barry, C.E. The biosynthesis of cyclopropanated mycolic acids in Mycobacterium tuberculosis. Identification and functional analysis of CMAS-2. J. Biol. Chem. 1995, 270, 27292–27298. [Google Scholar] [CrossRef] [PubMed]
- Munch, R.; Hiller, K.; Grote, A.; Scheer, M.; Klein, J.; Schobert, M.; Jahn, D. Virtual Footprint and PRODORIC: An integrative framework for regulon prediction in prokaryotes. Bioinformatics 2005, 21, 4187–4189. [Google Scholar] [CrossRef]
- Whiteside, M.D.; Winsor, G.L.; Laird, M.R.; Brinkman, F.S. OrtholugeDB: A bacterial and archaeal orthology resource for improved comparative genomic analysis. Nucleic Acids Res. 2013, 41, D366–D376. [Google Scholar] [CrossRef]
- Ferreras, J.A.; Gupta, A.; Amin, N.D.; Basu, A.; Sinha, B.N.; Worgall, S.; Jayaprakash, V.; Quadri, L.E. Chemical scaffolds with structural similarities to siderophores of nonribosomal peptide-polyketide origin as novel antimicrobials against Mycobacterium tuberculosis and Yersinia pestis. Bioorgan. Med. Chem. Lett. 2011, 21, 6533–6537. [Google Scholar] [CrossRef]
- Lun, S.; Guo, H.; Adamson, J.; Cisar, J.S.; Davis, T.D.; Chavadi, S.S.; Warren, J.D.; Quadri, L.E.; Tan, D.S.; Bishai, W.R. Pharmacokinetic and in vivo efficacy studies of the mycobactin biosynthesis inhibitor salicyl-AMS in mice. Antimicrob. Agents Chemother. 2013, 57, 5138–5140. [Google Scholar] [CrossRef]
- Gobin, J.; Moore, C.H.; Reeve, J.R.; Wong, D.K.; Gibson, B.W.; Horwitz, M.A. Iron acquisition by Mycobacterium tuberculosis: Isolation and characterization of a family of iron-binding exochelins. Proc. Natl. Acad. Sci. USA 1995, 92, 5189–5193. [Google Scholar] [CrossRef] [PubMed]

| Disrupted Gene or Promoter/5′ UTR 1 | Mutant Isolate 2 | Insertion Site 3 | Genome Coordinates 4 |
|---|---|---|---|
| eccA3 promoter | M68 | ATTCATGGC::Tn::ATTCATGGC | 2261555–2261563 |
| M74 | CCCTTCACC::Tn::CCCTTCACC | 2261304–2261312 | |
| eccA3 | M20 | GCCACATCC::Tn::GCCACATCC | 2261245–2261253 |
| M26 | GAGGTAGGAC::Tn::GAGGTAGGAC | 2260629–2260637 | |
| M49 | GTTCCAGACC::Tn::GTTCCAGACC | 2260292–2260300 | |
| M54 | GCCCAGGGT::Tn::GCCCAGGGT | 2260677–2260685 | |
| M65 | ACTCGAGGT::Tn::ACTCGAGGT | 2260934–2260942 | |
| M73 | GCCTCGGCC::Tn::GCCTCGGCC | 2260327–2260335 | |
| M86 | GTCGTGGGG::Tn::GTCGTGGGG | 2260705–2260713 | |
| eccB3 | M6 | GCCTCGCAC::Tn::GCCTCGCAC | 2258894–2258902 |
| M59 | GGCCTGCAC::Tn::GGCCTGCAC | 2258929–2258937 | |
| M76 | GAGCACCGG::Tn::GAGCACCGG | 2259061–2259069 | |
| eccC3 | M1 | GATCAATACC::Tn::GATCAATACC | 2257252–2257260 |
| M23 | CAGCTGGGA::Tn::CAGCTGGGA | 2256557–2256565 | |
| M52 | CGCCAGCGG::Tn::CGCCAGCGG | 2255501–2255509 | |
| M58 | ATGTTGGGGG::Tn::ATGTTGGGGG | 2254359–2254367 | |
| M79 | GCCCTGCAC::Tn::GCCCTGCAC | 2256146–2256154 | |
| M80 | GGCCTCGGC::Tn::GGCCTCGGC | 2254127–2254135 | |
| eccD3 | M75 | GCGCCAGGC::Tn::GCGCCAGGC | 2250160–2250168 |
| M77 | GATCAGACC::Tn::GATCAGACC | 2249549–2249557 | |
| eccE3 | M5 | GGCCAGCAT::Tn::GGCCAGCAT | 2247334–2247342 |
| M41 | TGCCAACGG::Tn::TGCCAACGG | 2246719–2246727 | |
| M62 | GGCTTGTCC::Tn::GGCTTGTCC | 2246741–2246749 | |
| mycP3 | M22 | GTCGCGCAC::Tn::GTCGCGCAC | 2248622–2248630 |
| M44 | ACTCAGTGC::Tn::ACTCAGTGC | 2247566–2247574 | |
| M53 | GCGCAACGC::Tn::GCGCAACGC | 2248266–2248274 | |
| M57 | GGGTTTGAC::Tn::GGGTTTGAC | 2248632–2248640 | |
| M61 | GCGCAACGC::Tn::GCGCAACGC | 2248266–2248274 | |
| M69 | GGCATACAC::Tn::GGCATACAC | 2247626–2247634 | |
| M78 | GACCAATTC::Tn::GACCAATTC | 2248147–2248155 | |
| esxH | M2 | AGTTGAAAG::Tn::AGTTGAAAG | 2251565–2251573 |
| M70 | CACCGGCGT::Tn::CACCGGCGT | 2251538–2251546 | |
| M72 | GGTCAGCAC::Tn::GGTCAGCAC | 2251493–2251501 | |
| M84 | GCCAGGCGG::Tn::GCCAGGCGG | 2251424–2251432 | |
| ppe4 | M7 | GTCCAGCCC::Tn::GTCCAGCCC | 2252181–2252189 |
| M45 | CTGCTGGGT::Tn::CTGCTGGGT | 2253289–2253297 | |
| M47 | GGCCAGTCC::Tn::GGCCAGTCC | 2251991–2251999 | |
| M51 | CTCCTGCAC::Tn::CTCCTGCAC | 2252431–2252439 | |
| M60 | CTCCTGCAC::Tn::CTCCTGCAC | 2252431–2252439 | |
| M63 | CTCCTGCAC::Tn::CTCCTGCAC | 2252431–2252439 | |
| M66 | TCTCCGAGG::Tn::TCTCCGAGG | 2252097–2252105 | |
| M67 | AAGCCAAGC::Tn::AAGCCAAGC | 2252171–2252179 | |
| M71 | CAGCAGCGC::Tn::CAGCAGCGC | 2253481–2253489 | |
| M81 | CCTCGTATG::Tn::CCTCGTATG | 2252754–2252762 | |
| M82 | CCACCAAGA::Tn::CCACCAAGA | 2252676–2252684 | |
| M85 | GGCGAAGCC::Tn::GGCGAAGCC | 2252167–2252175 | |
| M87 | GGGCGGCCA::Tn::GGGCGGCCA | 2252946–2252954 | |
| M88 | TGCCGAGGC::Tn::TGCCGAGGC | 2252329–2252337 | |
| pe5 | M64 | GCCCAGCTC::Tn::GCCCAGCTC | 2253630–2253638 |
| MAB_4275c5 | P5 | GTAGCCGAA::Tn::GTAGCCGAA | 4348013–4348021 |
| MAB_2276c | M50 | GAGCATGCGC::Tn::GAGCATGCGC | 2324048–2324056 |
| MAB_4537cpromoter | M55 | CAAGGAAAT::Tn::CAAGGAAAT | 4620490–4620498 |
| MAB_1912c | M56 | TCCAGGACC::Tn::TCCAGGACC | 1909545–1909553 |
| MAB_4783 | M83 | AGCGCATGT::Tn::AGCGCATGT | 4893827–4893835 |
Publisher’s Note: MDPI stays neutral with regard to jurisdictional claims in published maps and institutional affiliations. |
© 2022 by the authors. Licensee MDPI, Basel, Switzerland. This article is an open access article distributed under the terms and conditions of the Creative Commons Attribution (CC BY) license (https://creativecommons.org/licenses/by/4.0/).
Share and Cite
Bythrow, G.V.; Farhat, M.F.; Levendosky, K.; Mohandas, P.; Germain, G.A.; Yoo, B.; Quadri, L.E.N. Mycobacterium abscessus Mutants with a Compromised Functional Link between the Type VII ESX-3 System and an Iron Uptake Mechanism Reliant on an Unusual Mycobactin Siderophore. Pathogens 2022, 11, 953. https://doi.org/10.3390/pathogens11090953
Bythrow GV, Farhat MF, Levendosky K, Mohandas P, Germain GA, Yoo B, Quadri LEN. Mycobacterium abscessus Mutants with a Compromised Functional Link between the Type VII ESX-3 System and an Iron Uptake Mechanism Reliant on an Unusual Mycobactin Siderophore. Pathogens. 2022; 11(9):953. https://doi.org/10.3390/pathogens11090953
Chicago/Turabian StyleBythrow, Glennon V., Manal F. Farhat, Keith Levendosky, Poornima Mohandas, Gabrielle A. Germain, Barney Yoo, and Luis E. N. Quadri. 2022. "Mycobacterium abscessus Mutants with a Compromised Functional Link between the Type VII ESX-3 System and an Iron Uptake Mechanism Reliant on an Unusual Mycobactin Siderophore" Pathogens 11, no. 9: 953. https://doi.org/10.3390/pathogens11090953
APA StyleBythrow, G. V., Farhat, M. F., Levendosky, K., Mohandas, P., Germain, G. A., Yoo, B., & Quadri, L. E. N. (2022). Mycobacterium abscessus Mutants with a Compromised Functional Link between the Type VII ESX-3 System and an Iron Uptake Mechanism Reliant on an Unusual Mycobactin Siderophore. Pathogens, 11(9), 953. https://doi.org/10.3390/pathogens11090953







